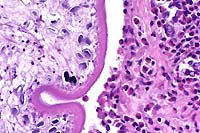

Results
AFIP Wednesday Slide Conference - No. 8
21 October 1998
- Conference Moderator:
Dr. D. Earl Green, Diplomate, ACVP
NCRR LSS SSB, Bldg. 28A, Room 117
28 Library Drive, MSC 5210
Bethesda, MD 20892-5210
NOTE: Click on images for larger views. Use browser's
"Back" button to return to this page.
Return to WSC Case Menu
-
- Case I - MK98-2222 (AFIP 2639069)
-
- Signalment: Adult, male, cynomolgus macaque (Macaca
fascicularis)
-
- History: This monkey was part of an experiment investigating
the effects of intraocular inoculation of an adenovirus. At termination
of the scientific study, the animal was humanely euthanized via
administration of intravenous barbiturates, the tissues of interest
were collected, and the carcass was placed in refrigeration.
A complete necropsy was performed 48 hours later. Incidental
lesions were found in the lungs.
-
- Gross Pathology: The macaque was well hydrated and
well muscled with adequate stores of yellow fat. Along the ventral
margins of the left cardiac and diaphragmatic lung lobes there
were multiple 2-4 mm diameter spherical, yellowish-white, hard
nodules in the pleura. Some nodules were attached to the pleura
by a thin fibrous tag, while others caused adhesions between
the parietal and pulmonary pleura. The mandibular and tracheobronchial
lymph nodes were slightly enlarged and homogeneously gray. The
heart, liver, kidneys, spleen, pancreas, gastrointestinal tract,
and reproductive tract appeared normal.
-
- Laboratory Results: Acid-fast stains of two mineralized
pleural nodules and two tracheobronchial lymph nodes were negative.
Contributor's Diagnosis and Comments:
Morphologic diagnosis: Granulomata, verminous, subpleural,
multifocal, mild, chronic.
Etiologic diagnosis: Pulmonary mesocestodiasis (pulmonary
tetrathyridiosis).
Etiology: Larval Mesocestoides species (tetrathyridia).
-
- The lung has multiple, discrete, subpleural granulomas which
each contain a single immature cestode that lacks a bladder wall.
The cestode larvae are nonsegmented and contain an invaginated
scolex. Occasional sections of the larvae show the presence of
suckers in the invaginated canal. Larvae have multiple small
lightly basophilic calcareous corpuscles. The reaction is characterized
by fibrous septal thickening, type II pneumocyte hyperplasia
and a mix of inflammatory cells consisting of eosinophils, macrophages,
plasma cells, and lymphocytes. A layer of degenerate inflammatory
cells lies adjacent to the cestodes. The pleura is thickened
by chronic pleuritis.
-
- Differential diagnosis includes Diphyllobothrium species,
Mesocestoides species, and Echinococcus species. Because the
cestodes lack bladder walls, Echinococcus (hydatid cysts) was
ruled out. Histologically, the invaginated scolex, absence of
a bladder wall, and the 4 suckers are consistent with Mesocestoides.
-
- Mesocestoides species are members of the order Cyclophyllidea
and are found in many parts of the world, including Africa, Asia
and the United States. They can live in a wide range of hosts,
but are particularly widespread in carnivores. The life cycle
of Mesocestoides is incompletely understood and still largely
unknown, but there are thought to be two metacestode stages and
two intermediate hosts. The first stage metacestode probably
occurs in a coprophagous arthropod, with the second stage metacestode
occurring in a vertebrate. Mammals and reptiles are not infected
directly by eggs, but must ingest the larval form of the cestode
in the first intermediate host.
-
- The larval form of Mesocestoides is known as a tetrathyridium.
Tetrathyridia are flat, nonsegmented and contractile, 2 to 70
millimeters long, and resemble fine connective tissue strands.
In an unsuitable host, the tetrathyridia persist in an encapsulated
form until they are ingested by a definitive host. Once ingested
by a definitive host, the tetrathyridia develop to adults in
approximately 21 to 30 days. The adult worm is 30 to 150 centimeters
long and a maximum of 3 millimeters wide. It has an unarmed scolex
with 4 suckers and no rostellum. Each proglottid has one set
of male and female reproductive organs with a single genital
pore characteristically placed ventromedially. One feature unique
to Mesocestoides is the method used for asexual reproduction.
Other cestodes reproduce asexually by budding, but Mesocestoides
are able to reproduce asexually by developing a longitudinal
fissure that begins at the scolex.
-
- Generally, the larval cestodes are either encapsulated in
the retroperitoneal and subcutaneous tissues or are free in the
abdominal and thoracic cavities. There are reports of tetrathyridia
occurring in the scrotum, bladder, liver, intestines, and rarely
in the lungs of mammals, reptiles, birds and amphibians. When
the infection occurs in the pleural spaces, the cestodes are
generally free floating. Mesocestoides are seldom found in nonhuman
primates, and are exceptionally rare in macaques. When encountered
in macaques, the tetrathyridia are either free in the abdomen
or encysted in the mesentery, and rarely involve the lung. Previous
reports have referred to the chronic infection as "pearl
disease" in primates because of the size, shape and color
of the verminous granulomas.
 2x
obj
2x
obj  40x
obj
40x
obj
- Case 8-1 . Lung. The 2x view shows 3 profiles of cestode
larva surrounded by a dense inflammatory infiltrate forming a
granuloma adjacent to the pleura surface. Surrounding alveoli
have mild alveolar emphysema and thickened alveolar septa. At
40x, multiple calcarious corpuscles (blue bodies with clear halos)
are scattered within the mesenchyme of the larva. The tegument
has a thick eosinophilic, 15-20u, smooth surfaced cuticle. The
surrounding interstitium is fibrotic with moderate numbers of
infiltrating eosinophils and fewer macrophages and lymphocytes.
-
- AFIP Diagnosis: Lung: Granulomas, eosinophilic, multiple,
with larval cestodes, cynomolgus monkey (Macaca fascicularis),
nonhuman primate, etiology consistent with Mesocestoides sp.
-
- Conference Note: Conference participants identified
a cestode parasite characterized by a thick tegument, the presence
of calcareous corpuscles within a parenchymatous body, and an
invaginated unarmed scolex; a few sections contained identifiable
suckers. Muscle cells divide the cortex from the medulla, identifying
the cestode as a cyclophyllidian, rather than a pseudophyllidian
such as a sparganum. Additionally, spargana contain a bothrial
slit without suckers. Also included in the differential diagnosis
discussed by conference participants was the coenurus form of
taeniid metacestodes. Coenuri in tissue sections occur as single
or loculated fluid-filled cysts in which many nodular invaginated
scolices are present in clusters on the inner wall. The inverted
scolices also contain suckers, and in all species, except Coenurus
bovis, hooks may be found on the rostellum.
-
- In most instances, the scolex of Mesocestoides sp. is invaginated
when examined in tissue sections. During collection of live tetrathyridia
for use in feeding experiments, the cestode larvae are freed
from tissue nodules by placement into digestive juices. After
release into the medium, the scolex of the tetrathyridium may
be induced to evaginate by subjecting the larva to alternating
temperatures between an incubator (37 °C) and refrigerator
(4 °C).
-
- Traditionally, determination of species within the genus
Mesocestoides has relied on inoculation of encysted and free
tetrathyridia into definitive hosts and sacrificing the animals
after tapeworm proglottids become evident in the feces of the
inoculated subjects. Identification of the cestode species is
based upon the morphology of adult tapeworms harvested from the
definitive hosts at necropsy. In practice, however, these feeding
experiments are not always successful or feasible.
-
- Recently, tapeworm larvae were identified in dogs with peritoneal
infections caused by Mesocestoides sp. using polymerase chain
reaction amplification of cestode DNA. While the protocol did
not determine the exact species of Mesocestoides infecting the
dog, refinement of the technique may eventually eliminate the
necessity of feeding trials for parasite speciation.
-
- There is abundant proteinaceous fluid filling alveoli in
some sections of lung. This fluid is considered artifact caused
by refrigeration of the carcass and the effects of intravenous
barbiturate euthanasia. Tissue sections may have originated from
dependent areas of lung. There were no clinical signs of pulmonary
edema, and the microscopic features suggestive of antemortem
edema, such as dilated lymphatics, are not evident in the examined
sections.
Contributor: Pathology Unit, Veterinary Resources Program,
NCRR, National Institute of Health, 9000 Rockville Pike, Bethesda,
MD 20892.
References:
- 1. Sasseville VG, et al.: A case of pulmonary cestodiasis
in a simian immunodeficiency virus-infected pigtailed macaque
(Macaca nemestrina) in which virus-infected leukocytes are present
within the lesion. J Med Primatol 25:251-256, 1996.
- 2. Fincham JE, et al.: Pleural Mesocestoides and cardiac
shock in an obese vervet monkey (Cercopithecus aethiops). Vet
Pathol 32:330-333, 1995.
- 3. Hubbard GB, et al.: Mesocestoides infection in captive
olive baboons (Papio cynocephalus anubis). Lab Anim Sci 43:625-627,
1993.
- 4. Guillot LM, Green LC: Pulmonary cestodiasis in a cynomolgus
monkey (Macaca fasicularis). Lab Anim Sci 24:158-160, 1992.
- 5. Schmidt GD, Roberts LS: Tapeworms. In: Foundations of
Parasitology, pp. 373-398, Times Mirror/Mosby College Publishing,
St. Louis, Missouri, 1985.
- 6. Reid WA, Reardon MJ: Mesocestoides in the baboon and its
development in laboratory animals. J Med Primatol 5:345-352,
1976.
- 7. Wong MM, Conrad HD: Parasitic nodules in the macaques.
J Med Primatol 1:156-171, 1972.
- 8. Houser WD, Paik SK: Hydatid disease in a macaque. J Amer
Vet Med Assoc 159:1574-1577, 1971.
- 9. Specht D, Voge M: Asexual multiplication of Mesocestoides
tetrathyridia in laboratory animals. J Parasitol 51:268-272,
1965.
- 10. Barker IK, Van Dreumel AA, Palmer N: Infectious and parasitic
diseases of the gastrointestinal tract. In: Pathology of Domestic
Animals, Jubb KVF, Kennedy PC, Palmer N, eds., 4th ed., vol.
2, pp. 287-292, Academic Press, 1993.
- 11. Crosbie PC, et al.: Diagnostic procedures and treatment
of eleven dogs with peritoneal infections caused by Mesocestoides
spp. J Amer Vet Med Assoc 213:1578-1583, 1998.
-
- Case II - 97F377 (AFIP 2642181)
-
- Signalment: Nine-month-old, Nile tilapia, male, piscine,
Tilapia nilotica.
-
- History: This tilapia was one of several submitted
for diagnostic evaluation following an outbreak of disease in
a large indoor recirculating aquaculture facility. Mortalities
approaching 20% were occurring throughout the facility, in both
fingerling and grow-out tanks. Despite the mortalities, a large
portion of the fish population continued to feed aggressively.
The primary clinical signs reported by the producer were exophthalmia,
cloudy eyes and aimless circling near the water's surface. With
the exception of high dissolved carbon dioxide levels, water
quality parameters were within acceptable limits. The producer
reported periodic spikes in nitrite levels and low dissolved
oxygen levels in some tanks during the period leading up to the
initial mortalities.
Gross Pathology: Although gross lesions varied between
individuals, this particular tilapia, weighing 0.75 lb (0.34
kg), exhibited changes representative of the diseased population
as a whole. The fish was submitted live, euthanized, and necropsied
immediately. There was generalized darkening of the skin accompanied
by reddening of the pectoral fin bases. Severe exophthalmia,
corneal opacification, and cloudy intraocular exudate were present
bilaterally. The abdomen was distended by copious amounts of
slightly opaque watery fluid containing flecks of fibrin. The
liver, spleen and kidney were diffusely pale. Splenomegaly was
marked, and fibrinous material was loosely adhered to its capsular
surface. The pericardial chamber also contained a cloudy exudate,
and fibrin was adhered to the epicardium. The meninges were congested,
and cerebrospinal fluid appeared excessive and slightly opaque.
Additional lesions present in other fish included subcutaneous
abscesses, particularly in the caudal peduncle, at the base of
the pectoral fins, and along the ventral margin of the mandible.

- Case 8-2. Gross Viscera. Shows cloudy opacity of anterior
chamber of eye (ophthalmitis), splenomegaly, and fibrin tags
on the splenic capsule (fibrinous peritonitis) and heart (fibrinous
epicarditis). Gills have been removed (note stumps of branchial
arches). The branchial chamber is partly coated with a tan (fibrinous)
exudate. The kidney (?) is very pale and/or covered with fibrin.
Laboratory Results: Streptococcus iniae was isolated in
pure culture from the brain, liver and spleen.
-
- Contributor's Diagnoses and Comments:
- 1. Brain, meningitis, granulomatous, moderate, with intralesional
cocci.
2. Membranous labyrinth, otitis interna, granulomatous, moderate
to severe.
- Etiology: Streptococcus iniae.
-
- Streptococcus iniae was first reported in the United States
in 1994 from a Texas tilapia farm experiencing 75% mortalities.
The disease then quickly surfaced around the United States, probably
due to rapid expansion of the industry and the movement of infected
fingerlings around the country. Since that time, it has become
the most significant disease problem facing the tilapia industry.
The disease has subsequently been reported in hybrid striped
bass cultured in association with infected tilapia. Cases of
bacterial meningoencephalitis in tilapia and rainbow trout appeared
in Israel in 1986. The offending agent was given the new species
name of S. shiloi and was not properly identified as S. iniae
until 1995. Streptococci, with biochemical properties similar
to S. iniae, have been isolated from cultured tilapia and other
fish species in Japan dating back to 1979.
Streptococcus iniae is a b-hemolytic coccus first isolated from
a captive Amazon River dolphin in 1976. The bacterium is not
classifiable by the traditional Lancefield typing system, and
dolphin biotypes are reportedly non-pathogenic to fish. In the
experience of this lab, cases of S. iniae present as either an
acute fulminating septicemia or in a more chronic form limited
to the central nervous system. In the acute septicemic form,
gross lesions, including any or all or those described above,
may be present. Microscopic lesions include meningoencephalitis,
perineuritis, polyserositis, epicarditis, myocarditis, and cellulitis.
Cocci can sometimes be seen in hematoxylin & eosin stained
sections, but are readily evident when stained with tissue Gram
stains. In these cases, the bacteria can be readily isolated
from most organs and serous membranes in large numbers on blood
or brain heart infusion agars. In chronic cases, small effete
granulomas with caseous centers may be present in parenchymatous
organs, but active inflammation is usually limited to the central
nervous system. Typically, the organism can be cultured only
from the brain in these cases.
-
- Infections are primarily a problem in closed recirculating
culture systems and are much less common in ponds. This is probably
related to the higher stocking densities and problems of water
quality (such as high nitrite levels) encountered in recirculating
culture systems. This would suggest that stress may play a role
in outbreaks of disease. While typically susceptible to oxytetracycline,
potentiated sulfonamides and ampicillin, treatment failures using
medicated feeds are common. Depopulation of affected facilities,
disinfection and restocking with disease free fish are currently
the best means of eliminating the organism. During the winter
of 1995-1996, invasive infections due to S. iniae were reported
from the Toronto area in human patients who had suffered skin
injuries while handling fresh fish, including tilapia. Infections
included cellulitis of the hand and one case of endocarditis.
All cases were successfully treated with antibiotics.
-
 4x
obj
4x
obj
- Case 8-2. Otic vesicle, Brain. The otic vesicle is
heavily infiltrated by inflammatory cells and fibrin, and contains
a mineralized otolith. The connective tissue between the brain
and otic vesicle is similarly infitrated by abundant inflammatory
cells.
 Brown
& Brehn, 40x obj
Brown
& Brehn, 40x obj
- Case 8-2 . Skull. Some macrophages in the exudate
surrounding the otic vesicle contain abundant Gram positive cocci.
 20x
obj
20x
obj
- Case 8-2.Gill filaments and lamella. The interlamellar
space is partially filled between most gill lamella by an infiltrate
of macrophages, lymphocytes, and fewer mucus cells and/or epithelial
cells.
-
- AFIP Diagnoses:
- 1. Brain; meninges; otic labyrinth; pericardium; and skeletal
muscle: Inflammation, histiocytic and lymphoplasmacytic, multifocal,
moderate, with intrahistiocytic cocci, Nile tilapia (Tilapia
nilotica), piscine.
2. Gill: Branchitis, lymphoplasmacytic, multifocal, mild, with
epithelial hyperplasia.
-
- Conference Note: Epicarditis, choroiditis, and ventriculitis
are present in some sections. Additionally, some sections contain
amphophilic, amorphous bodies within the otolabyrinth; these
may be otoliths.
-
- Conference participants found the intense histiocytic inflammatory
response to this streptococcal organism rather unique. Streptococcal
infection is typically associated with an intensely neutrophilic,
suppurative inflammatory response. In one report of experimental
and field infections (S. difficile and S. shiloi) in cultured
fish, the primary microscopic changes were in the brain and consisted
of subarachnoid hemorrhages and parenchymal mononuclear inflammatory
infiltrates with giant cells.
-
- A report of granulomatous valvular endocarditis is described
in humans in which Streptococcus viridans, an alpha-hemolytic
streptococus, was cultured and identified histologically in diseased
aortic valves in two individuals. Fibrinoid necrosis and histiocytic
granulomas were observed histologically, and streptococci were
found in the cytoplasm of macrophages. Another unique, though
dissimilar, lesion has been reported in streptococcal bacteremia
in Singapore house geckos. Histomorphologic changes were described
as multiple, nodular, expansile colonies of cocci primarily affecting
the lungs and kidneys, often in the absence of an inflammatory
reaction. The minimal inflammatory infiltrates that were present
consisted of occasional macrophages, lymphocytes, and rare granulocytes
at the edges of the bacterial colonies. Chains of cocci were
embedded within an amphophilic, homogenous material, identified
ultrastructurally as a thick peptidoglycan layer and a thinner
glycocalyx surrounding the bacterial cell wall. In rats, local
or systemic injection of peptidoglycan-polysaccharide polymers
from the bacterial cell walls of group A streptococci leads to
acute inflammation which can develop into chronic, spontaneously
relapsing granulomatous inflammation in several organs. The histiocytic
inflammatory response in tilapia infected with S. iniae may be
a function of the immune response in fish and other poikilothermic
animals, coupled with the structural and biochemical properties
of non-Lancefield streptococci which may incite an atypical inflammatory
response.
-
- Whether recent human infections of S. iniae represent a new
zoonotic pathogen or cases of previously unrecognized disease
remains unknown. Cellulitis in humans occurring spontaneously
or associated with injury is most often due to S. pyogenes or
Staphylococcus aureus, and cultures of such lesions are usually
nondiagnostic or not performed. Under certain circumstances,
the beta-hemolysis of S. iniae on culture media may not be evident,
and it may be considered a contaminant. The reports of human
infection seem to coincide with the recent identification of
the organism in cultured fish and support the possibility that
S. iniae may be a newly emerging pathogen.
-
- Another streptococcal species capable of producing zoonotic
infection is Streptococcus suis. Outbreaks of S. suis septicemia
and meningitis occur in pigs, especially under adverse environmental
conditions. Human infections with S. suis have been described
in individuals handling live or slaughtered infected pigs. The
portal of entry for the organism is thought to be the skin. Human
infections with S. suis and S. iniae seem to share several clinical
and epidemiological similarities. Changes in production, storage,
distribution, and preparation of food may provide increased opportunity
for human exposure to pathogenic organisms.
-
- Contributor: Department of Pathology, School of Veterinary
Medicine, Louisiana State University, Baton Rouge, LA 70803.
-
- References:
- 1. Perera RP, et al.: Streptococcus iniae associated with
mortality of Tilapia nilotica x T. aurea hybrids. J Aquatic Animal
Health 6:335-340, 1994.
- 2. Eldar A, Bejerano Y, Livoff A, Horovitcz A, Bercovir H:
Experimental streptococcal meningoencephalitis in cultured fish.
Vet Microbiol 43:33-40, 1995.
- 3. Eldar A, Berejano Y, Bercovier H: Streptococcus shiloi
and Streptococcus difficile: Two new streptococcal species causing
a meningoencephalitis in fish. Cur Microbiol 28:139-143, 1994.
- 4. Weinstein MR, et al.: Invasive infections due to a fish
pathogen, Streptococcus iniae. New Eng J Med 337:589-594, 1997.
- 5. Gassel AM, et al.: [Granulomatous endocarditis caused
by streptococcus]. Pathologe 15:40-43, 1994.
- 6. Sartor RB, Herfarth H, Van Tol EAF: Bacterial cell wall
polymer-induced granulomatous inflammation. Methods 9:223-247,
1996.
- 7. McNamara TS, Gardiner CH, Harris RK, Hadfield TL, Behler
JL: Streptococcal bacteremia in two Singapore house geckos. J
Zoo Wildl Med 25:161-166, 1994.
-
- Case III - 7261-P-1 (AFIP 2637890)
-
- Signalment: Four-year-old, female baboon (Papio cynocephalus/anubis).
History: The animal received an autologous stem cell transplant
24 hours following irradiation with 1020cGy of radiation over
two days (split 510cGy each day). At approximately 25 days post-engraftment
(28 days post-irradiation), the animal presented with primary
complaint of hematuria, anemia, leukopenia and thrombocytopenia.
-
- Contributor's Diagnoses and Comments:
- 1. Kidney:
a. Tubular degeneration and necrosis, hemoglobinuric, multifocal,
mild to moderate.
b. Glomerulopathy, membranous, global, mild to moderate.
c. Nephritis, lymphoplasmacytic, fibrosing, multifocal, mild
to moderate with multifocal hemorrhage.
-
- 2. Large intestine:
a. Hemorrhage, proprial and submucosal, coalescing, severe, acute.
b. Arteriopathy and periarteriolar fibrosis, submucosal, multifocal,
mild.
3. Heart:
a. Cardiac fibrosis, moderate with mild multifocal lymphocytic
epicarditis.
b. Epicardial and endocardial hemorrhage, multifocal, mild, acute.
- Etiology: Erythrocytic parasitism (suggestive of Babesia
sp.).
-
- This animal's acute decline and nephropathy were interpreted
to be associated with a hemolytic crisis secondary to erythrocytic
parasitism. The morphology of the erythrocytic parasite was most
suggestive of babesiosis. This infection has been previously
documented in baboons (1) and has previously been recognized
in animals undergoing a similar protocol of irradiation, bone
marrow transplantation or repeated blood transfusion in our facility.
The organism can be difficult to appreciate in the submitted
sections. The submitted 2x2 color transparency illustrates the
organisms at 100X.
-
- This infection was facilitated by immunosuppression secondary
to total body irradiation and failure of the subsequent stem
cell engraftment. Numerous chronic lesions in the submitted sections
of kidney, heart and large intestine can be attributed to this
irradiation (2,3). These include glomerulopathy, mild fibrosing
nephritis, mild arteriopathy (characterized by mild hyaline changes
in arteriolar media and periarterial fibrosis), multifocal cardiac
fibrosis, and multifocal hemorrhage (secondary to thrombocytopenia).
 100x
obj
100x
obj
- Case 8-3. Kidney. One or more refractile protozoa
are found within many RBCs of congested interstitial capillaries.
There is fibrillar to amorphous proteinaceous material within
a collecting duct.
 40x
obj
40x
obj
- Case 8-3 . Kidney. The glomerulus contains increased
numbers of mesangial cells which compress glomerular capillaries.
Adjacent tubules are filled with eosinophilic material forming
hyaline casts.
 Movat
Stain, 4x obj
Movat
Stain, 4x obj
- Case 8-3. Cardiac muscle. Myocardial muscle is partly
replaced by fibrous connective tissue (fibrosis).
 4x
obj
4x
obj
- Case 8-3. Colon. The lamina propria is markedly expanded
by diffuse hemorrhage which distorts and separates the mucosa
from the underlying tunica muscularis.
-
- AFIP Diagnoses:
- 1. Kidney: Tubular epithelial degeneration and necrosis,
multifocal, mild to moderate, with intratubular proteinaceous
casts and erythrocytic debris, and intraerythrocytic piroplasms,
baboon (Papio cynocephalus/anubis), nonhuman primate.
2. Kidney; heart, atrium; large intestine (per contributor),
arteries: Fibrinoid necrosis, multifocal, with perivascular hemorrhage
and fibrin deposition.
3. Kidney: Glomerulopathy, membranous, global, multifocal, mild
to moderate.
4. Heart, atrium: Contraction band necrosis, multifocal.
5. Heart, atrium: Fibrosis, multifocal, mild.
6. Large intestine, lamina propria (per contributor): Hemorrhage,
diffuse, severe.
-
- Conference Note: This case was studied in consultation
with the Departments of Cardiovascular Pathology and Genitourinary
Pathology. Small arteries within the atrium have swollen endothelium,
and there is expansion of the tunica media by hyalinized eosinophilic
material, interpreted as fibrinoid change. Fibrin deposition
is present within the adventitia of some vessels. Myocyte contraction
band necrosis is also present, as are multifocal areas of fibrosis.
Similar arterial changes are present within the kidney. Many
glomeruli are hypercellular and contain increased amounts of
mesangial matrix; global and segmental synechiae are present
in some glomeruli. Severe hemorrhage is observed in the lamina
propria of the large intestine, making tissue identification
difficult.
-
- Multifocally, some kidney tubules are filled by an eosinophilic
homogenous material interpreted as proteinaceous fluid, while
a few tubules contain fibrin and sloughed epithelial cells. Still
other tubules contain moderate amounts of a more brightly eosinophilic,
globular to crystalline material interpreted to be hemoglobin.
Protein droplets occur within tubular epithelial cells, especially
within proximal convoluted tubules. Histochemical stains performed
at the AFIP demonstrate abundant iron within tubules and in tubular
epithelial cells.
-
- The histologic lesions in this baboon can be briefly summarized
as membranous glomerulopathy, vascular fibrinoid change in the
heart and kidney, severe hemorrhage in the lamina propria of
the large intestine, and hemoglobinuric nephrosis. Conference
participants found it difficult to separate the microscopic lesions
of irradiation from those of babesiosis. Membranous glomerulopathy,
hemorrhage in the large intestine, and vascular changes observed
in several organs are most consistent with irradiation effect;
however, a contribution to the vascular lesions by concurrent
babesiosis cannot be excluded. Hemoglobinuric nephrosis, as evidenced
by extensive hemoglobin pigment within tubules and tubular epithelium,
is not related to radiation, and is most likely secondary to
parasite-induced hemolysis.
-
- The vascular changes are characteristic of radiation effect.
In general, the entire vessel is affected by irradiation, although
the endothelium is the most sensitive part. The pathologic effects
on endothelial cells become evident when they attempt to divide,
usually 3-4 weeks post-irradiation. The old endothelium fails
to become replaced by new endothelial cells, leading to exposure
of the underlying basement membrane, consumption of platelets,
thrombocytopenia, and hemorrhage. Decreased or absent platelet
production due to irradiation-induced bone marrow suppression
exacerbates the thrombocytopenia and hemorrhage.
-
- Babesiosis is a tick borne disease caused by microorganisms
of the genus Babesia. Transfusion transmitted infections may
also occur. There are approximately 100 known species which infect
a wide variety of animals, including cattle, horses, dogs, cats,
swine, sheep, donkeys, goats, raccoons, skunks, fowl, wild rodents
and ruminants, and monkeys. The pathogenicity of babesia is directly
related to the species and strains infecting a given animal.
Host age and immunologic response generated against the parasite
are also factors in the disease. Hemolytic anemia and multiple
organ dysfunction account for most of the clinical signs observed
in animals with babesiosis. Disseminated intravascular coagulation
can be a fatal complication in canine babesiosis. Tissue hypoxia
due to anemia, shock, and vascular stasis, results in release
of cytokines, and widespread inflammation and damage to multiple
organs. In experimentally infected dogs, hypoxia appears to be
more important than hemoglobinuria in producing damage to the
kidneys.
Contributor: Department of Comparative Medicine, University
of Washington, Seattle, WA 98195-7190.
-
- References:
- 1. Weyhrich JT, et al.: Piroplasmosis in transfused, immunosuppressed
baboons. Lab Anim Sci 43:390, 1993.
- 2. Mostofi FK, Berdjis CC: Radiopathology of the kidney.
In: Pathology of Irradiation, Berdjis CC ed., pp. 597, Williams
& Wilkins Co., Baltimore, MD, 1971.
- 3. Berdjis CC: The cardiovascular system. In: Pathology of
Irradiation, Berdjis CC ed., pp. 377, Williams & Wilkins
Co., Baltimore, MD, 1971.
- 4. Taboada J: Babesiosis. In: Infectious Diseases of the
Dog and Cat, Green CE ed., 2nd ed., pp. 473-481, W.B. Saunders,
Philadelphia, PA, 1998.
-
- Case IV - U2579 (AFIP 2641488)
-
- Signalment: Two-year-old Atlantic salmon (Salmo salar).
-
- History: This fish was from a population reared in
sea water net pens held in the Bay of Fundy, New Brunswick, Canada.
The population at risk was experiencing steadily increasing mortality
over several weeks. Clinical signs included anorexia, inability
to hold position in the water column, and respiratory distress
(listlessness).
Gross Pathology: Unilateral to bilateral exophthalmos,
marked petechial to suffusive ventral hemorrhage, and mild branchial
pallor were prominent external signs. Internally, affected fish
had moderate amounts of serosanguinous to hemorrhagic peritoneal
fluid, and congested lower intestines, pyloric caeca and spleens.
Liver congestion was rarely observed (1/10), as were intramuscular,
perivisceral and peritoneal petechiae. All fish were off feed.
On section, copious amounts of blood flowed freely from the kidney.
-
- Laboratory Results: Samples submitted from the population
for bacteriology were negative. Clinical pathology/hematology
was not completed on this group of fish, but previous evaluations
of similarly affected populations showed evidence of marked anemia
in some fish (Byrne et al., 1998). Virus isolation on the salmon
head kidney (SHK) cell line produced cytopathic effect consistent
with that previously reported for the orthomyxovirus known to
be the causative agent of infectious salmon anemia (ISA) in Norwegian
pen-reared Atlantic salmon (Dannevig et al., 1995). Confirmation
of this finding was completed by IFAT using a monoclonal antibody
to the ISA virus produced in Norway (Falk and Dannevig, 1995)
and RT-PCR using primer series similarly identified by Norwegian
workers (Mjaaland et al., 1997). Electron microscopy of gill
tissue from field cases in New Brunswick (see 2x2 photo) revealed
the presence of viral particles in lamellar capillary endothelium
of appropriate size (90-120 nm) and morphology consistent with
the orthomyxovirus identified as the causative agent of ISA in
Norway (Hovland et. al., 1994; Nylund et. al., 1995).
-

- Case 8-4. Electron micrograph of gill endothelium.
Multiple oval shaped electron dense virus-like particles free
in the cytosol appear to be budding from several profiles (right)
of smooth endoplasmic reticulum (SER). Multiple mitochondria
in the upper half of the image have mild expansion of the inner
compartment.
-
- Contributor's Diagnoses and Comments:
1. Hepatic necrosis, congestion and hemorrhage, multifocal, acute,
moderate.
2. Renal interstitial congestion and hemorrhage, diffuse, acute,
severe.
3. Renal tubular necrosis, multifocal, acute, moderate.
- Etiology: Orthomyxovirus.
Primary histological lesions were noted in the liver and kidney.
Liver pathology was characterized by a range of changes, from
mild diffuse sinusoidal congestion to marked peliosis and hemorrhage,
often accompanied by multifocal to bridging regions of coagulative
necrosis. Affected regions of liver rarely contained a granulocytic
infiltrate. In some fish, mild perivascular cuffing by a mixed
leukocyte population was evident, but this was not a consistent
finding. The kidney also presented with sinusoidal congestion
and marked interstitial hemorrhage. In the more severely affected
fish, multifocal acute tubular necrosis, with eosinophilic casting
was also present and considered pathognomonic for the disease
(Mullins and Groman, submitted; Byrne et. al., 1998). Other tissues
(not present on slides) with congestion included filamental arterioles
of the gill, splenic sinusoids, vasculature of the pyloric caeca/intestinal
lamina propria, and visceral mesenteries. Erythrophagia was a
consistent finding in all cases, especially prominent in the
spleen.
-
- Mortalities ascribed to infectious salmon anemia in the Bay
of Fundy were first thought to have surfaced in the summer of
1996. At that time, however, pathology was primarily restricted
to the kidney (as noted above), and the term hemorrhagic kidney
syndrome (HKS) was adopted (Byrne et al., 1998). Significant
effort was made, without success, during the autumn and winter
of 1996-1997 to identify a cause for this syndrome, including
submission of frozen sections to Norway for IFAT stain for the
ISA virus. In the summer of 1997, with the aid of the Norwegian
SHK cell line, ISA virus was finally isolated and confirmed as
the virus causing mortality in fish from the Bay of Fundy.
-
- It is noteworthy that, during this period, the pathological
profile changed significantly to that presented here, especially
in naive fish which entered sea water in the spring of 1997 and
subsequently contracted the disease. The difference in pathological
presentation between the ISA as seen in Norway (and more recently
in Scotland) and that described in New Brunswick is significant
enough to suggest that there are at least 2 strains of the virus,
i.e. the Norwegian strain causing primarily liver pathology (Evensen
et al., 1991; Speilberg et al., 1995), and the New Brunswick
strain targeting the kidney.
-
- ISA is currently a serious problem for the salmon farming
industry in New Brunswick (Canada), Norway and Scotland, and
efforts are underway to intensively survey salmon populations
for the disease as well as develop a vaccine.
 10x
obj
10x
obj
- Case 8-4. Kidney. Hematopoietic cells are largely
replaced by hemorrhage and congestion which expands the interstitium
and separates tubules.
 40x
obj
40x
obj
- Case 8-4. Kidney. Multifocally, tubular epithelium
is necrotic.
 10x
obj
10x
obj
- Case 8-4. Multifocally and randomly throughout the
hepatic parenchyma, there are pale zones of hepatocellular necrosis
(loss of cell detail, karyolysis, pyknosis, & cell loss).
- AFIP Diagnoses:
- 1. Trunk kidney: Congestion and hemorrhage, diffuse, moderate,
Atlantic salmon (Salmo salar), piscine.
2. Liver, hepatocytes: Degeneration and necrosis, multifocal.
3. Kidney: Necrosis, tubular epithelium, multifocal.
4. Spleen: No significant lesions.
-
- Conference Note: Infectious salmon anemia (ISA) is
a viral disease of farmed salt water Atlantic salmon first reported
in Norway in 1984. The etiologic agent of ISA is an enveloped
RNA virus with structural characteristics consistent with an
orthomyxovirus. The virus replicates in endothelial cells, endocardium,
and leukocytes. The disease is characterized by severe anemia,
leukopenia and high mortalities. Pathological changes include
congestion of the liver, spleen and foregut, hemorrhagic liver
necrosis, ascites, pale gills, and petechiae in the viscera.
-
- In July 1996 increased moribund and dead farmed Atlantic
salmon were observed on Canada's eastern seaboard with no identified
etiology. Clinically, affected fish were lethargic, anorectic,
and lacked external lesions. Clinicopathological findings included
anemia, hypoproteinemia, hypernatremia, and hyperchloremia. Gross
lesions found during necropsy included multifocal reddening of
the kidney, pale gills, exophthalmos, ascites, and splenomegaly.
The major histopathological findings were renal interstitial
hemorrhage and acute tubular necrosis with tubular casts. The
disease was termed hemorrhagic kidney syndrome (HKS) of Atlantic
salmon. While a virus was suspected as the underlying cause,
the etiology was not determined until late in 1997 when an orthomyxovirus
was isolated from diseased Canadian Atlantic salmon at the New
Brunswick laboratory.
-
- The differences in the gross and histologic findings of ISA
virus in Norwegian and Canadian salmon with HKS are probably
multifactorial. The variation in Atlantic salmon stock, viral
strain, water temperatures, infectious dose, age of fish, immune
status, and concomitant infections may act as variables that
influence the pathogenesis and clinicopathologic presentation
of the disease. In addition to the kidney lesions of HKS described
in 1996, Canadian Atlantic salmon have subsequently developed
hepatic, branchial, and enteric lesions typical of ISA. Recent
archival reviews of Norwegian case submissions of ISA identified
the presence of renal lesions similar to those described in New
Brunswick, Canada. Eventual comparison of the genomic sequences
may help clarify potential differences in viral strains.
-
- Contributor: Atlantic Veterinary College, University
of Prince Edward Island, Charlottetown, PEI C1A 4P3, CANADA.
-
- References:
- 1. Byrne PJ, MacPhee DD, Ostland VE, Johnson G, Ferguson
HW: Haemorrhagic kidney syndrome of Atlantic salmon, Salmo salar
L. J Fish Dis 21:81-91, 1998.
- 2. Dannevig BH, Falk K, Namork E: Isolation of the causal
virus of infectious salmon anaemia (ISA) in a long-term cell
line from Atlantic salmon head kidney. J Gen Virol 76:1353-1359,
1995.
- 3. Evensen Ø, Thorud KE, Olsen YA: A morphological
study of the gross and light microscopic lesions of infectious
anaemia in Atlantic salmon (Salmo salar). Res Vet Science 51:215-222,
1991.
- 4. Falk K, Dannevig BH: Demonstration of infectious salmon
anaemia (ISA) viral antigens in cell cultures and tissue sections.
Vet Res 26:499-504, 1995.
- 5. Hovland T, Nylund A, Watanabe K, Endresen C: Observation
of infectious salmon anaemia virus in Atlantic salmon, Salmo
salar L. J Fish Dis 17:291-296, 1994.
- 6. Mjaaland S, Rimstad E, Falk K, Dannevig BH: Genomic characterization
of the virus causing infectious salmon anaemia in Atlantic salmon
(Salmo salar L.): An orthomyxo-like virus in a teleost. J Virol
71:7681-7686, 1997.
- 7. Mullins J, Groman D: Infectious salmon anaemia in salt
water Atlantic salmon in New Brunswick. Bulletin European Assoc
Fish Pathol 18:110-116, 1998.
- 8. Nylund A, Hovland T, Watanabe K, Endresen C: Presence
of infectious salmon anaemia virus (ISAV) in tissues of Atlantic
salmon, Salmo salar L, collected during three separate outbreaks
of the disease. J Fish Dis 18:108-111, 1995.
- 9. Speilberg L, Evensen O, Dannevig BH: A sequential study
of the light and electron microscopic liver lesions of infectious
anemia in Atlantic salmon. Vet Pathol 32:466-478, 1995.
-
- Ed Stevens, DVM
Captain, United States Army
Registry of Veterinary Pathology*
Department of Veterinary Pathology
Armed Forces Institute of Pathology
(202)782-2615; DSN: 662-2615
Internet: STEVENSE@afip.osd.mil
-
- * The American Veterinary Medical Association and the American
College of Veterinary Pathologists are co-sponsors of the Registry
of Veterinary Pathology. The C.L. Davis Foundation also provides
substantial support for the Registry.
Return to WSC Case Menu
 2x
obj
2x
obj 40x
obj
40x
obj

 4x
obj
4x
obj
 Brown
& Brehn, 40x obj
Brown
& Brehn, 40x obj
 20x
obj
20x
obj
 100x
obj
100x
obj
 40x
obj
40x
obj
 Movat
Stain, 4x obj
Movat
Stain, 4x obj
 4x
obj
4x
obj

 10x
obj
10x
obj
 40x
obj
40x
obj
 10x
obj
10x
obj